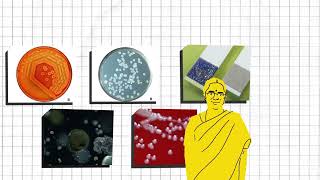

Quest Alliance prepares young learners in India with the skills, mindsets, and support systems they need to thrive in life, learning, and work.
Vision: A world where all young people take charge of their future and drive equitable social and economic progress.
Mission: We innovate for learning ecosystems to be future ready by creating and embedding tech-enabled learning experiences for young people to thrive in their careers.
Goal: We will impact one million learners and 25000 educators across the country by 2029.
Know more: www.questalliance.net/
Shared 2 months ago
213 views
Shared 2 months ago
72 views
Shared 2 months ago
58 views
Shared 2 months ago
94 views
Shared 2 months ago
75 views
Shared 4 months ago
194 views
Shared 4 months ago
167 views
Shared 5 months ago
11K views
Shared 6 months ago
494 views
Shared 6 months ago
614 views
Shared 7 months ago
420 views
Integrating Imagination in Learning: Futures Thinking as a Pedagogy | Quest for Better Futures| Ep 8
Shared 7 months ago
228 views
Shared 7 months ago
188 views
Shared 8 months ago
413 views
Shared 9 months ago
318 views
Shared 9 months ago
997 views
Shared 10 months ago
140 views
Shared 10 months ago
371 views
Shared 10 months ago
5K views
Shared 10 months ago
59 views
Shared 11 months ago
10K views
Shared 1 year ago
248 views
Shared 1 year ago
145 views
Shared 1 year ago
188 views
Shared 1 year ago
234 views
Shared 1 year ago
370 views
Shared 1 year ago
290 views
Shared 1 year ago
1K views
Shared 1 year ago
70 views
Shared 1 year ago
544 views
Shared 1 year ago
107 views
Shared 1 year ago
813 views
Shared 1 year ago
1.4K views
Shared 1 year ago
1.2K views
Shared 1 year ago
233 views
Shared 2 years ago
47 views
Shared 2 years ago
64 views
Shared 2 years ago
36 views
Shared 2 years ago
18 views